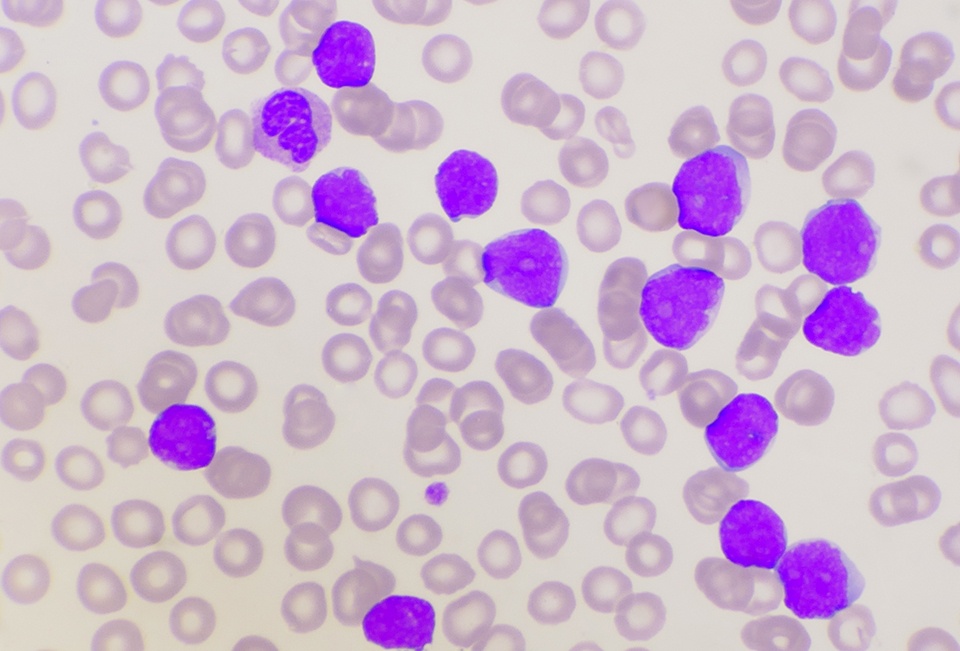

Patrick Daly
Patrick Daly
Articles by Patrick Daly
Patrick DalyColorectal Cancer | March 19, 2025
Maintenance with cetuximab monotherapy appeared to improve PFS and OS in patients with metastatic colorectal cancer.Patrick DalyGEP-NETs | March 19, 2025
A study found key tumor heterogeneities, including Ki-67 indices, might contribute to disease progression in GEP-NETs.Patrick DalyGEP-NETs | March 19, 2025
Lu-177-dotatate in PRRT appeared to treat GEP-NETs, though prior internal radiation may impede responses or worsen survival.Patrick DalyColorectal Cancer | March 19, 2025
Fruquintinib meaningfully improved overall survival in patients with refractory metastatic colorectal cancer versus placebo.Patrick DalyColorectal Cancer | March 19, 2025
Systemic chemotherapy did not show any benefit in patients with inoperable low-grade mucinous appendiceal adenocarcinoma.Patrick DalyGI Cancer | March 19, 2025
Eradication therapy for chronic Helicobacter pylori (H. pylori) infection reduces the risk for gastric cancer (GC), ...Patrick DalyPancreatic Cancer | March 19, 2025
In a recent study, researchers investigated the value of serum exosomal and serum glypican 1 (GPC-1) in predicting ...Patrick DalyPancreatic Cancer | March 19, 2025
In a phase 1b trial, researchers evaluated the safety and efficacy profiles of combined S-1, irinotecan, and oxaliplatin ...Patrick DalyEsophageal Cancer | March 19, 2025
In a randomized controlled trial, published in the Journal of Cancer Research and Therapeutics, researchers compared ...Patrick DalyGastric Cancer | May 16, 2022
According to an article in BMC Cancer, the most accurate inflammation and nutritional biomarkers for predicting the ...Patrick DalyPancreatic Cancer | March 19, 2025
According to Dirk Weyhe and collaborating researchers, patients experience significantly reduced physical and ...Patrick DalyEsophageal Cancer | March 19, 2025
Researchers performed a randomized clinical trial to examine the efficacy of bevacizumab and gemcitabine plus cisplatin ...Patrick DalyColorectal Cancer | May 4, 2022
Researchers investigated the role of a protein in the molecules interacting with CasL (MICAL) family, MICAL-like protein ...Patrick DalyPancreatic Cancer | March 19, 2025
According to a study, published in Frontiers in Oncology, pancreatic ductal adenocarcinoma (PDAC) is one of the most ...Patrick DalyColorectal Cancer | March 19, 2025
Over half of colorectal cancers (CRCs) are wired to RAS/RAF/MEK/ERK pathway oncogenic signaling; However, the activity ...Patrick DalyPancreatic Cancer | March 8, 2022
According to an article, published in the International Journal of Radiation Oncology, Biology, Physics, there is a ...About Column
Contribute Column
 © 2025 Mashup Media, LLC, a Formedics Property. All Rights Reserved.
© 2025 Mashup Media, LLC, a Formedics Property. All Rights Reserved.